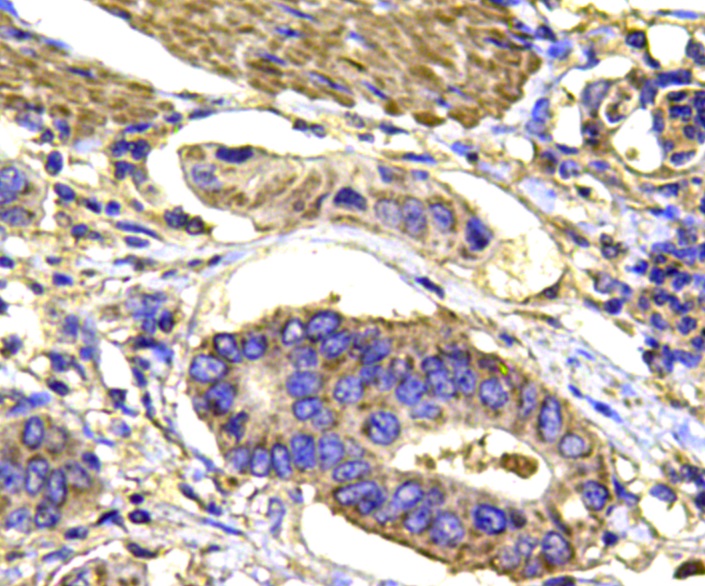

Anti-p38 Antibody
A32595
ApplicationsWestern Blot, ImmunoCytoChemistry, ImmunoHistoChemistry
Product group Antibodies
ReactivityHuman, Mouse
Overview
- SupplierAntibodies.com
- Product NameAnti-p38 Antibody
- Delivery Days Customer7
- Antibody SpecificityThis antibody detects endogenous levels of p38 and does not cross-react with related proteins.
- ApplicationsWestern Blot, ImmunoCytoChemistry, ImmunoHistoChemistry
- CertificationResearch Use Only
- ClonalityMonoclonal
- ConjugateUnconjugated
- HostMouse
- Scientific DescriptionMouse monoclonal antibody to p38
- ReactivityHuman, Mouse
- UNSPSC12352203